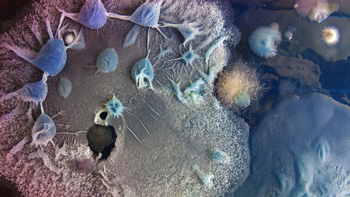
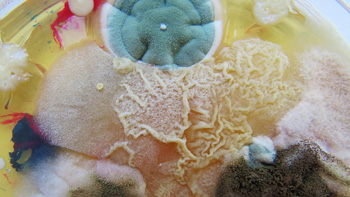

natura ekos
produção audiovisual para natura
o vídeo consiste na animação de aproximadamente 160 imagens, fruto da investigação calcada nos novos direcionamentos conceituais para a marca ekos da natura.
a seleção de imagens e roteiro foi feita pelo estúdio de design alles blau junto a uma antropóloga e uma redatora: uma pesquisa teórica, um posicionamento e essa investigação visual.
além da animação gráfica das imagens, produzimos também a trilha sonora original do vídeo.
com imagens de: cryoelectronic microscopy, desenho ianomami, vitor araújo, rogério assis, moara brasil, antonio dias, claudia andujar, maria isabel rueda, bruno zanardo, sheroanawe hakihiiwe, eduardo nóbrega, paula duró, aoruaura, urya sodoma, brus rubio churay, nasa, supercluster e galaaxia antennae, dasha plesen, luiz zerbini, zoroastra infinita, clarissa tossin, lua kali, jeff w. lichtman e joshua r., rember yahuarcani, laniakea supercluster, flora rebolo, povo shipibo-conibo, jaider esbel, anicka yi, daiara tukano, hilma af klint, tas visuals, man and wah, olafur eliasson.
* jan/2022
o vídeo consiste na animação de aproximadamente 160 imagens, fruto da investigação calcada nos novos direcionamentos conceituais para a marca ekos da natura.
a seleção de imagens e roteiro foi feita pelo estúdio de design alles blau junto a uma antropóloga e uma redatora: uma pesquisa teórica, um posicionamento e essa investigação visual.
além da animação gráfica das imagens, produzimos também a trilha sonora original do vídeo.
com imagens de: cryoelectronic microscopy, desenho ianomami, vitor araújo, rogério assis, moara brasil, antonio dias, claudia andujar, maria isabel rueda, bruno zanardo, sheroanawe hakihiiwe, eduardo nóbrega, paula duró, aoruaura, urya sodoma, brus rubio churay, nasa, supercluster e galaaxia antennae, dasha plesen, luiz zerbini, zoroastra infinita, clarissa tossin, lua kali, jeff w. lichtman e joshua r., rember yahuarcani, laniakea supercluster, flora rebolo, povo shipibo-conibo, jaider esbel, anicka yi, daiara tukano, hilma af klint, tas visuals, man and wah, olafur eliasson.
* jan/2022